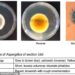

MacInnes, who graduated from a Western Australian acting academy in 2021, plays one of the two lead characters in The Deb, a musical comedy set in the Australian outback, having starred in a theatre production of the play in 2022. The movie was released in Australia this month.